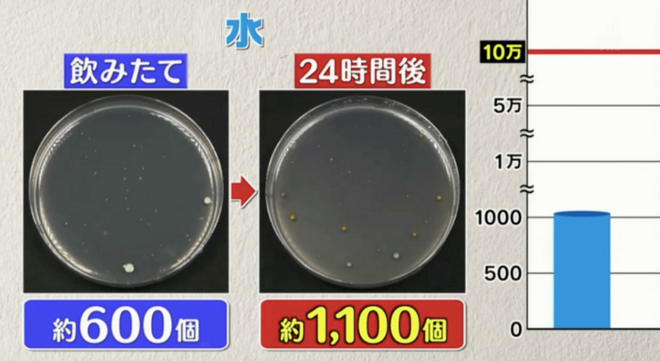

(Tổ Quốc) - Một chương trình truyền hình của Nhật Bản mới đây đã thí nghiệm 6 loại nước được sử dụng phổ biến nhất trong mùa hè để qua đêm ở nhiệt độ phòng, kết quả cho thấy lượng vi khuẩn tăng lên đột biến ở phần lớn các loại nước và có nguy cơ gây ngộ độc.
Vào ngày hè nóng nực, nhiều người thường mua đồ uống đóng chai để giải khát khi đi mua sắm, một số người không uống hết và quên bảo quản nó rồi hôm sau lại tiếp tục sử dụng. Vậy câu hỏi đặt ra là những loại nước này có gây ảnh hưởng đến sức khỏe khi để qua đêm ở nhiệt độ phòng hay không?
Các thử nghiệm của một chương trình truyền hình Nhật Bản mới đây đã phát hiện ra rằng đồ uống ban đầu sau khi mở nắp được bảo quản ở nhiệt độ phòng, sau 24 giờ, lượng vi khuẩn sẽ tăng mạnh, có loại lượng vi khuẩn tăng lên đến hơn 8000 lần so với lượng vi khuẩn ban đầu.

Các chuyên gia trong chương trình nêu trên nhận định lượng vi khuẩn này chủ yếu là Staphylococcus aureus (vi khuẩn tụ cầu vàng). Chúng xâm nhập vào chai nước qua miệng của chúng ta khi uống đồ uống đóng chai, khiến vi khuẩn nhân lên gấp nhiều lần. nếu lượng vi khuẩn tụ cầu vàng lớn hơn 100.000 trong 1g nước có thể gây ngộ độc thực phẩm.
Từ 600, sau 24 giờ, cà phê sữa chứa tới 5.17 triệu con vi khuẩn
Trong tập mới nhất chương trình Monday Late Show (月曜から夜ふかし) của Đài truyền hình TBS Nhật Bản, 6 loại đồ uống đóng chai phổ biến bao gồm nước, trà xanh, trà lúa mạch, nước cam, cà phê sữa và nước ngọt có ga đã được đưa vào trong cuộc thí nghiệm. Theo đó, với mỗi chai nước khác loại, người ta sẽ nếm thử 1 ngụm sau khi mở chai, sau đó vặn nắp lại, đặt đồ uống trong phòng có nhiệt độ 28 độ C và độ ẩm 70% trong 3 giờ.

Thử nghiệm với 6 loại nước được sử dụng phổ biến: nước, trà xanh, trà lúa mạch, nước cam, cà phê sữa và nước ngọt có ga.
Sau đó, người ta tiến hành kiểm tra sau 24 giờ số lượng Staphylococcus aureus có trong từng loại nước và so sánh với con số ban đầu thu được ngay sau khi uống 1 ngụm nước để thấy sự thay đổi.
Thử nghiệm cho thấy lượng vi khuẩn tăng đáng ngạc nhiên nhất là ở cà phê sữa, chỉ có 600 vi khuẩn ở thời điểm ban đầu. Sau 24 giờ thử nghiệm, con số này đã tăng lên hơn 5,17 triệu. Các chuyên gia trong chương trình giải thích cà phê sữa chứa hàm lượng đường và protein cao, cả hai chất dinh dưỡng này đều cần thiết cho sự phát triển của vi khuẩn, vì vậy số lượng vi khuẩn đã tăng lên đáng kể.

Lượng vi khuẩn trong cà phê sữa tăng từ 600 lên 5.17 triệu chỉ sau 24 giờ bảo quản ở nhiệt độ phòng.
Nước cam tươi đứng thứ 2 với lượng Staphylococcus aureus tăng từ 600 lên hơn 2,5 triệu. Mặc dù đây là nước cam tươi nguyên chất, không thêm đường, nhưng thực tế là nước cam đã có chứa đường fructose cũng có thể làm tăng sự phát triển của vi khuẩn.

Nước cam nguyên chất chứa đường fructose tạo điều kiện cho sự phát triển của vi khuẩn.
Nước ngọt có ga xếp thứ 3 với có hàm lượng đường cực cao, lượng vi khuẩn tăng từ 600 lên hơn 2,49 triệu. Mỗi 500ml loại nước này chứa khoảng 15 viên đường khiến vi khuẩn phát triển bùng nổ.

Lượng vi khuẩn trong nước ngọt có ga tăng từ 600 lên 2.49 triệu do hàm lượng đường cực cao.
Đối với trà lúa mạch mà người Nhật thích uống nhất, vì trà lúa mạch cũng chứa đường và protein, sau 24 giờ thử nghiệm, số lượng Staphylococcus aureus tăng lên gấp bội, từ 600 lên 3.700, tăng khoảng hơn 6 lần.

Nước mà mọi người uống hàng ngày được xếp hạng thứ 5 với lượng vi khuẩn đã tăng từ 600 lên khoảng 1.000.
Trà xanh có số lượng vi khuẩn gia tăng thấp nhất, thậm chí là tụt giảm đi, từ khoảng 600 chỉ còn khoảng 490. Các chuyên gia giải thích điều này là do trà xanh có chứa catechin, có tác dụng kháng khuẩn, do đó số lượng vi khuẩn trong đồ uống này không những không tăng mà còn giảm đi.

Staphylococcus aureus có thể gây ngộ độc thực phẩm
Chương trình chỉ ra rằng nếu có hơn 100.000 Staphylococcus aureus trong 1g đồ uống, nó có thể gây ngộ độc thực phẩm.
Thông tin từ Trung tâm Bảo vệ Sức khỏe Hồng Kông cho thấy Staphylococcus aureus có thể có trong mũi và bề mặt da của một số người khỏe mạnh, chủ yếu thông qua tiếp xúc trực tiếp với vết thương, dịch tiết và bề mặt bị ô nhiễm. Những người mang mầm bệnh này không có triệu chứng, nhưng vi khuẩn này đôi khi gây ra các bệnh, chẳng hạn như nhiễm trùng máu và ngộ độc thực phẩm.
Staphylococcus aureus cũng có thể gây nhiễm trùng da và mô mềm, như mụn mủ, áp xe hoặc nhiễm trùng vết thương. Đỏ, đau hoặc mủ có thể xuất hiện ở vị trí bị nhiễm bệnh. Các trường hợp nghiêm trọng có thể gây nhiễm trùng máu, viêm phổi hoặc viêm cân hoại tử.
Để tránh sự phát triển nhanh chóng của vi khuẩn này, chương trình khuyến khích mọi người sử dụng 2 phương pháp đơn giản:
- Đầu tiên là rót đồ uống ra cốc để tránh vi khuẩn bám trên da xâm nhập vào phần đồ uống còn lại trong chai, từ đó ngăn chặn sự phát triển của vi khuẩn.
- Hoặc bạn có thể đặt đồ uống trong tủ lạnh để làm lạnh, ngăn chặn hiệu quả sự phát triển của Staphylococcus aureus.
Tham khảo thêm tại Like Japan, Topick, TBS







